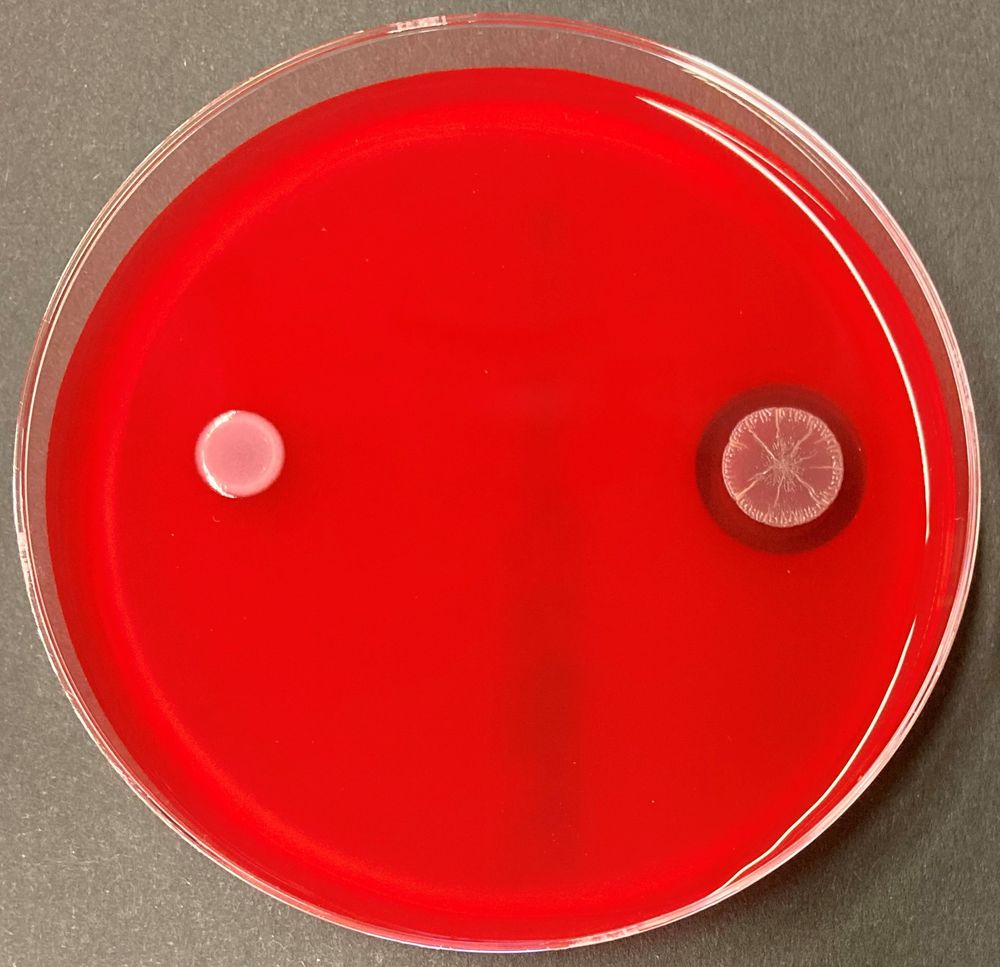
Comparison on blood agar: While the wild type of C. haemolyticum (right) shows a clear, bright hemolysis zone, the mutant lacking the gene cluster for the production of the jagaricins (left) lacks this zone.

Leo Dumjahn
@ldmjhn.bsky.social
PhD student in Biomolecular Chemistry @leibniz-hki.de. Interested in specialized metabolites involved in virulence of human-pathogenic bacteria.
Reposted by Leo Dumjahn
Schaut dieses Video. Verbreitet es weiter. Beobachtet, wie der Journalismus die entsprechende Entwicklung in Deutschland begleitet. www.youtube.com/watch?v=KHdU...

Why your government is about to raise YOUR taxes
YouTube video by Garys Economics
www.youtube.com
August 3, 2025 at 5:26 PM
Schaut dieses Video. Verbreitet es weiter. Beobachtet, wie der Journalismus die entsprechende Entwicklung in Deutschland begleitet. www.youtube.com/watch?v=KHdU...
Reposted by Leo Dumjahn
🤓New insights into biomass utilization: Researchers at @leibniz-hki.de and @mpi-ce.bsky.social I-CE have decoded the structure of the 🟡"Yellow Affinity Substance" from A. thermocellus, a pigment that binds cellulose and could boost biofuel production and antibiotic research.
#biotech #research #ERC
#biotech #research #ERC

June 30, 2025 at 11:39 AM
🤓New insights into biomass utilization: Researchers at @leibniz-hki.de and @mpi-ce.bsky.social I-CE have decoded the structure of the 🟡"Yellow Affinity Substance" from A. thermocellus, a pigment that binds cellulose and could boost biofuel production and antibiotic research.
#biotech #research #ERC
#biotech #research #ERC
Reposted by Leo Dumjahn
Pandorae bacteria produce #pandorabactins to steal #iron from other microbes, thus limiting competitors in the diseased lung of patients with cystic fibrosis or sepsis, as we show in @angewandtechemie.bsky.social Int Ed. #NewPaper #NaturalProducts #LeibnizHKI
🔎 PR: lmy.de/VoJXp
📖 Paper: lmy.de/mGWPV
🔎 PR: lmy.de/VoJXp
📖 Paper: lmy.de/mGWPV


June 19, 2025 at 9:27 AM
Pandorae bacteria produce #pandorabactins to steal #iron from other microbes, thus limiting competitors in the diseased lung of patients with cystic fibrosis or sepsis, as we show in @angewandtechemie.bsky.social Int Ed. #NewPaper #NaturalProducts #LeibnizHKI
🔎 PR: lmy.de/VoJXp
📖 Paper: lmy.de/mGWPV
🔎 PR: lmy.de/VoJXp
📖 Paper: lmy.de/mGWPV
Reposted by Leo Dumjahn
I'm happy that our latest study has been accepted in @angewandtechemie.bsky.social! This work elucidates the final steps of malleicyprol biosynthesis.
A big thank you to all co-authors for their contributions to this project.
Full article: onlinelibrary.wiley.com/doi/10.1002/...
A big thank you to all co-authors for their contributions to this project.
Full article: onlinelibrary.wiley.com/doi/10.1002/...
June 3, 2025 at 1:03 PM
I'm happy that our latest study has been accepted in @angewandtechemie.bsky.social! This work elucidates the final steps of malleicyprol biosynthesis.
A big thank you to all co-authors for their contributions to this project.
Full article: onlinelibrary.wiley.com/doi/10.1002/...
A big thank you to all co-authors for their contributions to this project.
Full article: onlinelibrary.wiley.com/doi/10.1002/...
Excited to share the second publication of my PhD published in @angewandtechemie.bsky.social! Using chemical synthesis, full in vitro reconstitution and trapping of intermediates, we elucidated the final steps in the biosynthesis of the virulence factor malleicyprol. 🧪
doi.org/10.1002/anie...
doi.org/10.1002/anie...

Thiotemplated Polyketide Chain Fusion and Reductive Cyclization Build the Reactive Butenolide Core of Malleicyprol
Malleicyprol, a virulence factor of notorious animal and human pathogens of the Burkholderia pseudomallei (BP) group, features a molecular cyclopropanol warhead linked to a reactive butenolide core. ...
doi.org
May 28, 2025 at 6:22 AM
Excited to share the second publication of my PhD published in @angewandtechemie.bsky.social! Using chemical synthesis, full in vitro reconstitution and trapping of intermediates, we elucidated the final steps in the biosynthesis of the virulence factor malleicyprol. 🧪
doi.org/10.1002/anie...
doi.org/10.1002/anie...
Reposted by Leo Dumjahn
„Karlheinz #Weißmann, einer der meinungsstärksten Vertreter des Konservatismus“. Geht’s noch, Schloss Ettersburg? Der Mann ist nicht konservativ, sondern radikaler #Geschichtsrevisionist und Vordenker der Neuen Rechten. Er gründete das rechtsextreme Institut für Staatspolitik in #Schnellroda.

May 20, 2025 at 6:27 AM
„Karlheinz #Weißmann, einer der meinungsstärksten Vertreter des Konservatismus“. Geht’s noch, Schloss Ettersburg? Der Mann ist nicht konservativ, sondern radikaler #Geschichtsrevisionist und Vordenker der Neuen Rechten. Er gründete das rechtsextreme Institut für Staatspolitik in #Schnellroda.
Reposted by Leo Dumjahn
My group is looking for a postdoc to explore novel chemistry in the moss microbiome! 🧪🌱🧫
If you have experience in natural product isolation and structural elucidation, apply now.
📅 Deadline: April 30, 2025
More info & apply here: 🔗 jobs.hki-jena.de/jobs/Postdoc...
If you have experience in natural product isolation and structural elucidation, apply now.
📅 Deadline: April 30, 2025
More info & apply here: 🔗 jobs.hki-jena.de/jobs/Postdoc...
April 3, 2025 at 2:53 PM
My group is looking for a postdoc to explore novel chemistry in the moss microbiome! 🧪🌱🧫
If you have experience in natural product isolation and structural elucidation, apply now.
📅 Deadline: April 30, 2025
More info & apply here: 🔗 jobs.hki-jena.de/jobs/Postdoc...
If you have experience in natural product isolation and structural elucidation, apply now.
📅 Deadline: April 30, 2025
More info & apply here: 🔗 jobs.hki-jena.de/jobs/Postdoc...
Reposted by Leo Dumjahn
🚨 New dual-use #Jagaricin function uncovered: it drives red blood cell destruction by C. haemolyticum, enabling infections while normally aiding survival via biofilms. A case of accidental virulence, as we show in #mBio. 🔎 doi.org/10.1128/mbio...
@microverse.bsky.social #ChemBioSys #NaturalProducts
@microverse.bsky.social #ChemBioSys #NaturalProducts

April 15, 2025 at 2:58 PM
🚨 New dual-use #Jagaricin function uncovered: it drives red blood cell destruction by C. haemolyticum, enabling infections while normally aiding survival via biofilms. A case of accidental virulence, as we show in #mBio. 🔎 doi.org/10.1128/mbio...
@microverse.bsky.social #ChemBioSys #NaturalProducts
@microverse.bsky.social #ChemBioSys #NaturalProducts
Reposted by Leo Dumjahn
Some bacteria use a chemical radar to protect themselves from predators: how this happens, was discovered by #UniJena, @leibniz-hki.de and @unibayreuth.bsky.social with our Cluster of Excellence @microverse.bsky.social, as they reported in "Cell". 🦠
➡️ www.uni-jena.de/en/307648/pr...
➡️ www.uni-jena.de/en/307648/pr...

April 3, 2025 at 1:26 PM
Some bacteria use a chemical radar to protect themselves from predators: how this happens, was discovered by #UniJena, @leibniz-hki.de and @unibayreuth.bsky.social with our Cluster of Excellence @microverse.bsky.social, as they reported in "Cell". 🦠
➡️ www.uni-jena.de/en/307648/pr...
➡️ www.uni-jena.de/en/307648/pr...
Second publication from my previous work in the Group of Prof. Schofield @ox.ac.uk! We show that silaproline-bearing derivatives of SARS-CoV-2 main protease inhibitors can convalently inhibit Mpro, resulting in viral progression inhibiton in cells. Great work everyone!
doi.org/10.1016/j.ej... 🧪
doi.org/10.1016/j.ej... 🧪
Redirecting
doi.org
April 9, 2025 at 1:01 PM
Second publication from my previous work in the Group of Prof. Schofield @ox.ac.uk! We show that silaproline-bearing derivatives of SARS-CoV-2 main protease inhibitors can convalently inhibit Mpro, resulting in viral progression inhibiton in cells. Great work everyone!
doi.org/10.1016/j.ej... 🧪
doi.org/10.1016/j.ej... 🧪
I am very excited to share the first work of my PhD published in mBio @asm.org! 🦠🧪 In short, we discovered why the opportunistic human pathogen Chromobacterium haemolyticum is hemolytic - the reason are jagaricins, a family of cyclic lipodepsipeptides! #secmet 1/2 journals.asm.org/doi/10.1128/...

Dual-use virulence factors of the opportunistic pathogen Chromobacterium haemolyticum mediate hemolysis and colonization | mBio
Despite the rising incidence of Chromobacterium haemolyticum as a serious opportunistic pathogen, there is limited information on whether the
competitive traits that ensure its survival in its freshwa...
journals.asm.org
April 4, 2025 at 9:00 AM
I am very excited to share the first work of my PhD published in mBio @asm.org! 🦠🧪 In short, we discovered why the opportunistic human pathogen Chromobacterium haemolyticum is hemolytic - the reason are jagaricins, a family of cyclic lipodepsipeptides! #secmet 1/2 journals.asm.org/doi/10.1128/...
Fun day with motivated students! 🦠🧪
👀 Science in action! At #FutureDay2025, students synthesized fluorescent dyes, observed fungi under the microscope, and even generated electricity from mud. Pure curiosity at work! 📸 Check out some highlights! www.leibniz-hki.de/en/news/exci...
🤝 @microverse.bsky.social
🤝 @microverse.bsky.social




April 3, 2025 at 6:46 PM
Fun day with motivated students! 🦠🧪
Reposted by Leo Dumjahn
#AllEyesOn our department Biomolecular Chemistry! We explore bacteria and fungi to study their microbial interactions, discover and identify pharmacologically relevant bioactive compounds or toxins and elucidate their biosynthetic pathways. lmy.de/rBnwi

February 15, 2025 at 9:36 AM
#AllEyesOn our department Biomolecular Chemistry! We explore bacteria and fungi to study their microbial interactions, discover and identify pharmacologically relevant bioactive compounds or toxins and elucidate their biosynthetic pathways. lmy.de/rBnwi

